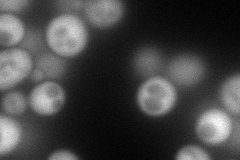
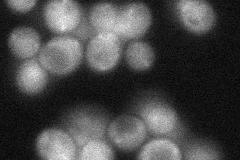
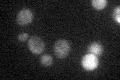

View description
Phosphoribosyl-5-amino-1-phosphoribosyl-4-imidazolecarboxiamide isomerase, catalyzes the fourth step in histidine biosynthesis; mutations cause histidine auxotrophy and sensitivity to Cu, Co, and Ni salts
Localization:
Intensity:
Fold change:
Significance:
-
C’ GFP library in SD

cytosol34.92 -
N' NOP1pr-GFP in SD
cytosol160.452 -
N' TEF2pr-mCherry in SD

cytosol223.65 -
N' NATIVEpr-GFP in SD
cytosol36.1536 -
N' TEF2pr-VC and Cyto-VN in SD

cytosol51.875 -
C’ GFP library in SD+DTT

cytosol25.470.72No -
C’ GFP library in SD+H2O2

cytosol36.951.05No -
C’ GFP library in Starvation Media
cytosol34.280.98No -
C’ GFP library on the background of Pup2-DaMP

cytosol -
C’ GFP library on the background of CCT mutant

cytosol32.38550.927194No
